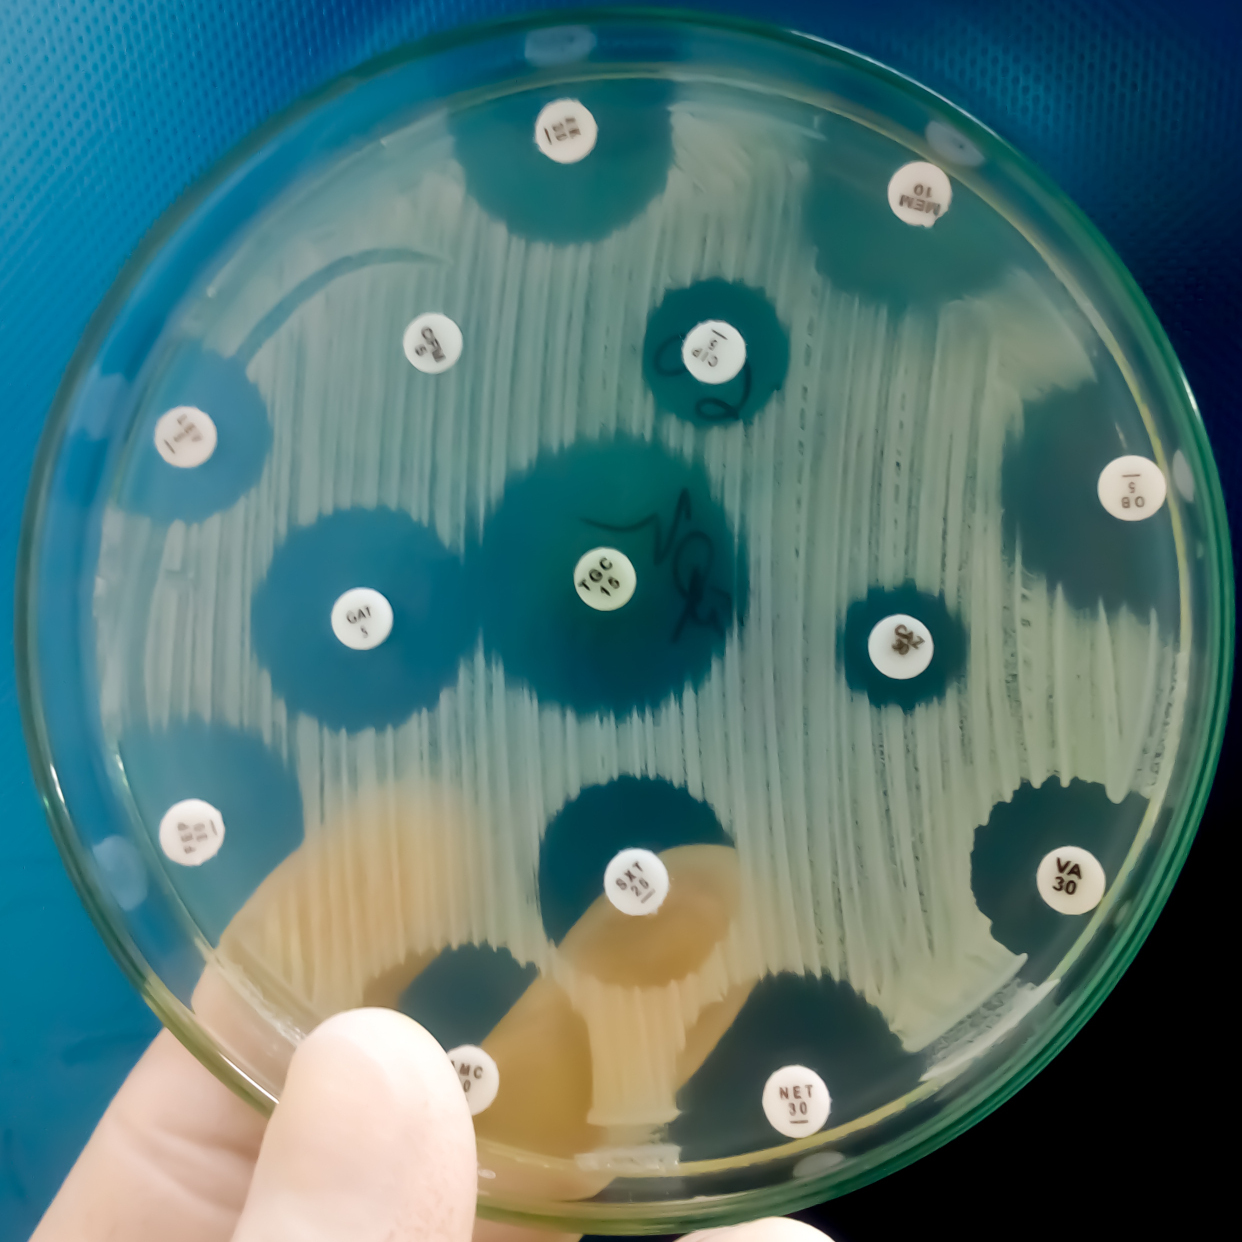

The EASI ecosystem combines modular instrumentation with ready-to-use assay panels. Researchers and operators can use the hardware for their own workflows or choose from our standard assay panels.
Molecular Analysis & Bioinformatics
Our Molecular Analysis and Bioinformatics Services

Biodiversity & Ecosystem Health
Monitor habitat composition and track ecological change.
Assay Overview
- Fish eDNA: species lists, biodiversity
- Invertebrates: macroinvertebrate indices
- Microbes: key functional groups
- Protists/Plankton: phytoplankton guilds
- Species tables, OTUs, Relative Abundance
Microbial Source Tracking
Trace and attribute fecal pollution sources, detect pathogens, aid remediation.
Assay Overview
- Human MST markers: HF183/BacR287
- Ruminant markers: Cow, Pig, Poultry, Dog, Gull
- Pathogens: E.coli (0157:H7), Norovirus GI/GII, Cryptosporidium, Giardia intestinalis, E. faecalis, E. faecium
- Gene copies per L (gc/L), Source Attribution


Biosecurity: Invasive Species
Detect or monitor invasive non-native species.
Assay Overview
- Broad or Targeted Species Assays
- Presence/Absence, Watchlist, Baseline reports
Antimicrobial Resistance (AMR)
Detect & Track ARG hotspots in wastewater, rivers, ports.
Assay Overview
- Core panel: intI1, sul1, blaTEM, blaCTX-M, qnrS, blaKPC, blaNDM, blaOXA-48-like, blaVIM, mcr-1
- ARG index, co-occurrence with MST markers

Sediment & Biofilm Analysis
Uncover legacy DNA and long-term microbial repositories in sediments and biofilms.
Assay Overview
- Metabarcoding and Biofilm Scrapes / Swabs
- Species tables, OTUs, Relative Abundance
Harmful Algal Bloom (HAB)
Detect bloom species and toxin potential.
Assay Overview
- Species tables, OTUs, Relative Abundance
